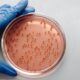

Le Centre africain pour le contrôle et la prévention des maladies (CDC Afrique) a indiqué le 16 juillet 2023, accorder la priorité à une réponse rapide aux maladies infectieuses émergentes dans le cadre des efforts visant à renforcer la résilience des systèmes de santé publique du continent.
L’Afrique est sur une bonne voie. Selon Jean Kaseya, directeur général du CDC Afrique, une réponse solide, dotée de ressources adéquates, opportune et bien coordonnée aux urgences de santé publique du continent, et en particulier aux épidémies, est un impératif. S’étant exprimé en marge du sommet de coordination de mi-année de l’Union africaine à Nairobi, il précise qu’il « est essentiel de maîtriser le lourd fardeau de la maladie en Afrique pour parvenir à la croissance et à la prospérité ». Sur la base des leçons tirées de la pandémie de Covid-19, le CDC Afrique aide les pays à élaborer des plans d’urgence en vue de futures épidémies afin d’éviter des décès massifs et des pressions sur les établissements de santé publique. En outre, le CDC Afrique travaille en partenariat avec les blocs régionaux pour renforcer la recherche, la surveillance, la notification et le suivi des maladies infectieuses comme Ebola, le virus de Marburg, la fièvre de la vallée du Rift et le paludisme. « L’amélioration de la fabrication locale de vaccins, de produits thérapeutiques et d’équipements de protection renforcera également la capacité des pays africains à répondre aux urgences sanitaires » a conclu le patron de CDC Afrique.
A propos de CDC
Africa CDC est une agence de santé continentale autonome de l’Union africaine créée pour soutenir les initiatives de santé publique des États membres et renforcer la capacité de leurs institutions de santé publique à détecter, prévenir, contrôler et répondre rapidement et efficacement aux menaces de maladies. Créé en janvier 2016 par la 26e Assemblée ordinaire des chefs d’État et de gouvernement et lancé officiellement en janvier 2017, Africa CDC est guidé par les principes de leadership, de crédibilité, d’appropriation, de délégation de pouvoirs, de diffusion rapide de l’information et de transparence dans l’exécution de ses missions. activités quotidiennes. L’institution sert de plate-forme aux États membres pour partager et échanger des connaissances et des enseignements tirés des interventions de santé publique.
Divine KANANYET

Comments are closed